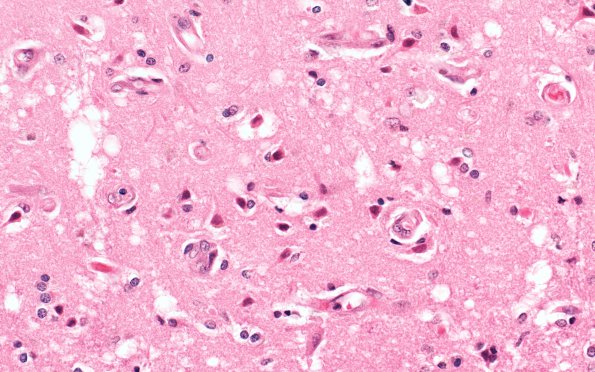
6B4 Laminar sclerosis (Case 6) H&E 40X

Table of Contents
Washington University Experience | VASCULAR | Infarct - (Pseudo) Laminar necrosis | 6B4 Laminar sclerosis (Case 6) H&E 40X
Other areas show a typical vacuolated cortex with numerous reactive astrocytes overlying a cortical lamina rich in hypoxic/ischemic changes (i.e., endothelial prominence, numerous neurons undergoing eosinophilic neuronal necrosis, etc., 6B4) (H&E)